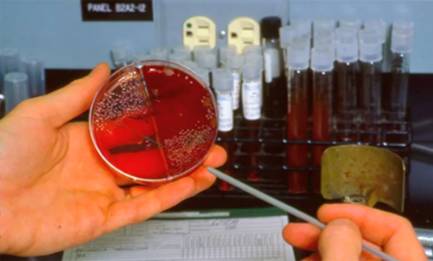

昨天我读到了迈克尔•格雷格博士(Dr. Michael Greger)的一篇很有意思的微博,说: “纯素者的血液循环抗癌能力增强近8倍。”显然, 这几个字引起了我的注意, 所以我按照上面提供的链接, 看了格雷格博士的NutritionFacts.org网站上的一个短视频,获得了更多的解释。
根据普里特金(Nathan Pritikin)研究基金会的一项研究,吃纯素饮食一年,血液抑制癌细胞生长的近8倍,而另一个类似的研究发现,两个星期的植物性饮食表现出对乳腺癌和结肠癌细胞防御能力显著增强。
第一项研究对象是一群不同饮食习惯的人士,把他们的血液分别滴入前列腺癌细胞生长的培养皿内, 看谁的血液更好地抑制肿瘤的生长。 结果发现, 按标准美国饮食(SAD)人士的血液,癌症的生长速度减缓9%, 而纯素食饮食一年的人的血液, 癌症的生长速度减缓了70% !
第二项研究是妇女和乳腺癌 , 每个个体只是纯素食饮食两周(不是一年)。这项研究测试了血液对抗癌症的能力,先测试标准饮食时的情况,然后让他们在纯素食饮食两周后进行测试。研究发现,纯素食饮食仅两周, 参与者的血液癌细胞的生长明显变缓慢, 甚至停止了。也就是说,在纯素食饮食两周后,同样个体的血液抗癌细胞的能力显著增强。
格雷格博士没有提及适度锻炼和适当的压力管理的重要性, 但这也应是一个因素。我想我们都同意,为了保持健康的生活方式,合理的饮食必须加上适当的锻炼和放松。
那么,你希望你体内有什么样的血液、 什么样的免疫系统为你运作呢? 最佳的道路是选择植物性饮食。
原文:Vegan Blood Fights Cancer Better